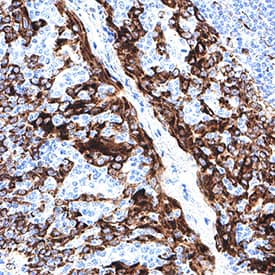

Human CKAP4/p63 Antibody
R&D Systems, part of Bio-Techne | Catalog # MAB11600


Key Product Details
Species Reactivity
Applications
Label
Antibody Source
Product Specifications
Immunogen
His128-Val602
Accession # Q07065
Specificity
Clonality
Host
Isotype
Scientific Data Images for Human CKAP4/p63 Antibody
Detection of Human CKAP4/p63 by Western Blot.
Western Blot shows lysates of HepG2 human hepatocellular carcinoma cell line and HT1080 human fibrosarcoma cell line. PVDF membrane was probed with 1 µg/ml of Mouse Anti-Human CKAP4/p63 Monoclonal Antibody (Catalog # MAB11600) followed by HRP-conjugated Anti-Mouse IgG Secondary Antibody (Catalog # HAF018). A specific band was detected for CKAP4/p63 at approximately 65 kDa (as indicated). This experiment was conducted under reducing conditions and using Western Blot Buffer Group 1.Detection of CKAP4/p63 in Human Colon.
CKAP4/p63 was detected in immersion fixed paraffin-embedded sections of human colon using Mouse Anti-Human CKAP4/p63 Monoclonal Antibody (Catalog # MAB11600) at 5 µg/ml for 1 hour at room temperature followed by incubation with the Anti-Mouse IgG VisUCyte™ HRP Polymer Antibody (Catalog # VC001). Before incubation with the primary antibody, tissue was subjected to heat-induced epitope retrieval using VisUCyte Antigen Retrieval Reagent-Basic (Catalog # VCTS021). Tissue was stained using DAB (brown) and counterstained with hematoxylin (blue). Specific staining was localized to the cell surface and cytoplasm. View our protocol for IHC Staining with VisUCyte HRP Polymer Detection Reagents.Detection of CKAP4/p63 in Human Placenta.
CKAP4/p63 was detected in immersion fixed paraffin-embedded sections of human placenta using Mouse Anti-Human CKAP4/p63 Monoclonal Antibody (Catalog # MAB11600) at 5 µg/ml for 1 hour at room temperature followed by incubation with the Anti-Mouse IgG VisUCyte™ HRP Polymer Antibody (Catalog # VC001). Before incubation with the primary antibody, tissue was subjected to heat-induced epitope retrieval using VisUCyte Antigen Retrieval Reagent-Basic (Catalog # VCTS021). Tissue was stained using DAB (brown) and counterstained with hematoxylin (blue). Specific staining was localized to the cell surface and cytoplasm. View our protocol for IHC Staining with VisUCyte HRP Polymer Detection Reagents.Applications for Human CKAP4/p63 Antibody
Immunocytochemistry
Sample: Immersion fixed HT-1080 cells and MG-63 human osteosarcoma cell line
Immunohistochemistry
Sample: Immersion fixed paraffin-embedded sections of human colon, sections of human placenta and sections of human tonsil
Simple Western
Sample: HepG2 human hepatocellular carcinoma cell line
Western Blot
Sample: HepG2 human hepatocellular carcinoma cell line and HT1080 human fibrosarcoma cell line
Formulation, Preparation, and Storage
Purification
Reconstitution
Formulation
Shipping
Stability & Storage
- 12 months from date of receipt, -20 to -70 °C as supplied.
- 1 month, 2 to 8 °C under sterile conditions after reconstitution.
- 6 months, -20 to -70 °C under sterile conditions after reconstitution.
Background: CKAP4/p63
CKAP4 (Cytoskeleton-associated protein 4; also CLIMP63 and p63) is a 63-64 kDa molecule that belongs to no known protein family. It is found intracellularly, and on the plasma membrane of select cells such as vascular smooth muscle and Type II Greater alveolar lung cells. CKAP4 has a bimodal distribution. First, it is embedded in the membrane of a compartment that links the ER with the Golgi apparatus. This localization is dependent upon its ability to form homooligomers, and its presence serves to anchor microtubules and direct the formation of tubular ER. Second, it is embedded in the plasma membrane and serves as a receptor for SP-A/surfactant protein-A (in lung) and tPA (in vessels). Human CKAP4 is a 602 amino acid (aa) type II transmembrane nonglycosylated protein. It contains a 106 aa N-terminal cytoplasmic region plus a 475 aa C-terminal luminal domain (aa 128-602). The luminal domain contains three coiled-coil regions (aa 130-214; 256-460; 533-602) plus three utilized phosphorylation sites. CKAP4 undergoes reversible palmitoylation. There are two potential isoform variants. One contains an alternative start at Met269, while another shows a deletion of aa 258-435. Over aa 128-602, human CKAP4 shares 82% aa sequence identity with mouse CKAP4.
Long Name
Alternate Names
Gene Symbol
UniProt
Additional CKAP4/p63 Products
Product Documents for Human CKAP4/p63 Antibody
Product Specific Notices for Human CKAP4/p63 Antibody
For research use only